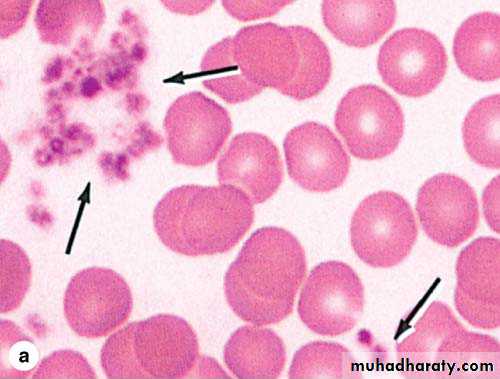

Lec . No. 8 Blood tissue
byAbeer hazim
• Blood is a fluid, it is a specialized connective tissue, Propelled mainly by rhythmic contractions of the heart, about five liters of blood in an average adult moves unidirectionally within the closed circulatory system.Blood
The primary components include:
1- Plasma.2- Formed elements circulating in the plasma include:
* Erythrocytes (Red blood cells).
* Leukocytes (white blood cells).
* Platelets.
collected blood in which clotting is prevented by the addition of anticoagulants (e.g. heparin, citrate), can be separated by centrifugation into layers that reflect its heterogeneity. Erythrocytes make up the bottom layer and their volume, normally about 45% of the total blood volume in healthy adults, it is called the hematocrit. Above this region buffy coat is white or grayish layer (about 1% volume) less dense than erythrocytes consists of leukocytes and platelets. Plasma is the yellowish translucent, slightly viscous supernatant comprising 55% at the top half of the centrifugation tube.
• Composition of whole blood
Functions of blood:• 1- Distribution:
- Transporting O2, CO2, metabolites, hormones, Nutrients.
• - Remove metabolic waste.
2- Regulation:
- Maintain body temperature.
- Maintain PH, and fluid volume.
3- Protection:
- Restrict loss blood at injury (clotting).
- Prevent infection (leukocytes).
Plasma
Plasma: the liquid in which peripheral blood cells are suspended, pH 7.4. Composed of water, electrolytes such as Na+ and Cl, 7% plasma proteins (such as albumin, fibrinogen, globulins), hormones, fats, amino acids, vitamins carbohydrates, lipoproteins as well as other substances.Serum:
Serum: the clear liquid that can be separated from clotted blood. Serum differs from plasma, serum does not contain white or red blood cells nor a clotting factors.Serum includes all proteins not used in blood clotting (coagulation) and all the electrolytes, antibodies, antigens, hormones, and any exogenous substances (e.g. drugs and microorganisms).
It is the clot that makes the difference between serum and plasma.
Blood CellsA. Erythrocytes ( RBC )
- A normal red blood cell is a biconcave disk, lack nuclei, and the cytoplasm is densely filled with hemoglobin, average RBC count ( 4.2 - 6.2 million/μl ), this biconcave shape provides a large surface area for facilitates gas exchange.
- Erythrocyte differentiation
includes loss of the nucleus
and all organelles, shortly
before the cells are released
by bone marrow into
the circulation.
- Erythrocyte have flexible membrane. Flexibility required for passage through capillaries and important for the normal low viscosity of blood. Cells frequently assume a cup shape in capillaries.
Life span: The mature erythrocyte has a life span of approximately 120 days in the circulation.
Function: Transport O2 and CO2. hemoglobin combined with O2 or CO2, forms oxyhemoglobin or carbaminohemoglobin, respectively.
B. Leukocytes (WBC)
Leukocytes are generally spherical cells have nuclei & organelles, no hemoglobin Unlike RBC, and inactive while suspended in circulating blood, but become amoeboid and motile after leaving the blood vessels and invading the tissues. Leukocytes migrate to the tissues where they become functional and perform various fuctions:* defend against pathogens
* remove toxins and wastes
* remove abnormal/damaged cells.
According to the type of cytoplasmic granules and the shape of their nuclei, leukocytes are divided into two groups:
• 1- Polymorphonuclear granulocytes: which have polymorphic nuclei with two or more lobes and this group includes the neutrophils, eosinophils, and basophils.
• Granules posses two types in their cytoplasm:
* Specific granules that bind neutral, basic or acidic stain and have specific functions.
* Azurophilic granules which are specialized lysosomes, stain darkly, and present at some level in all leukocytes.
2- mononuclear a granulocytes: do not have specific granules, but they do contain azurophilic granules (lysosomes). The nucleus is round or indented. This group includes lymphocytes and monocytes.
Types of human leukocytes
1- GranulocytesA- Neutrophils (Polymorphonuclear Leukocytes)
-Neutrophils are inactive and spherical while circulating, but become actively amoeboid during diapedesis and upon adhering to solid substrates, with nuclei- Having 2 to 5 lobes linked
by thin nuclear extensions.
-Constitute 60–70% of
circulating leukocytes.
Life span: neutrophils are short-lived cells with a half-life of 6–7 hours in blood and a life span of 1–4 days in connective tissues.
Functions: Neutrophils are the first line of defense against microorganisms, especially bacteria. They are active phagocytes of bacteria and other small particles using chemotaxis.
B- Eosinophils
-Eosinophils are far less numerous than neutrophils, constituting only 2–4% of leukocytes in normal blood.- This cell is about the same
size as a neutrophil, but with
a characteristic bilobed nucleus.
- The main identifying
characteristic is the abundance of large red specific
granules that are stained by eosin.
Functions:
- Defense against parasites such as helminthic worms and protozoa.
- Eosinophils modulate inflammatory responses in many ways.
- They are an important source of the factors mediating allergic reactions and asthma.
C- Basophils
Make up less than 1% of blood leukocytes and are therefore difficult to find in smears of normal blood.The nucleus is divided into two or more irregular lobes, which are often difficult to see because of the large, dark-staining specific granules.
-Basophilic specific granules
also contain much histamine and various
mediators of inflammation.
Function:
Although the basophil possesses phagocytic capabilities, it is mainly a secretory cell which mediates the hypersensitivity reaction.2- Agranulocytes
A- LymphocytesLymphocytes make 28 % of white blood cells, they are round cells. Mature lymphocytes show a spectrum of sizes ranging from small lymphocytes to larger forms.
-They contain a single, deeply-stained, spherical nucleus which can have a slight indentation.
life span: Lymphocytes vary in life span according to their specific functions; some live only a few days and others survive in the circulating blood or other tissues for many years.
They can be subdivided into functional groups according to surface molecules that can best be distinguished immunocytochemically:
- T lymphocytes. - B lymphocytes. - natural killer (NK) cells.
Function: Lymphocytes have diverse functional roles related to immune defense against invading microorganisms, foreign or abnormal antigens, and cancer cells.
B- Monocytes
Monocytes are the largest a granular leukocytes, derived from bone marrow, the nucleus is large eccentrically placed, and may be oval, kidney-shaped, or U-shaped.Constituting 5% of leukocytes in normal blood.
life span: Monocytes can live in the blood for 2 - 3 days, after which they move into the connective tissue, where they may remain for a few months or longer.
Functions:
- Circulating monocytes are precursor cells of macrophages.
- They ingest (phagocytize) and remove particulate matter, tissue debris, and infectious agents.
C. Platelets
Blood platelets (thrombocytes) are nonnucleated, dislike cell fragments (2–4) μm, derived from megakaryocytes in the bone marrow.
In stained blood smears, platelets often appear in clumps.
-Normal platelet counts
range from 200,000 to
400,000 /μl of blood.
- Platelets have a life
span of about 10 days.
Function of Platelets:
- promote blood clotting and preventing loss of blood.- help repair minor tears or leaks in the walls of blood vessels.
Hemopoiesis
The different blood cells have a relatively short life spans and must be renewed to maintain appropriate circulating levels. The process of renewal is known as hematopoiesis (hemopoiesis).All blood cells arise from a single type of stem cell in the bone marrow called pluripotent stem cell, because it can produce all cell types.
The pluripotent stem cells proliferate and form two major cell lineages; one for lymphocytes (lymphoid cells) and another for myeloid cells that develop in bone marrow (granulocytes, monocytes, erythrocytes, and megakaryocytes). Early in their development, lymphoid cells migrate from the bone marrow to the thymus, lymph nodes, spleen, and other lymphoid tissues.
Erythropoiesis (RBCs):
Process of formation and differentiation of RBCs. the kidney secretes a hormone called erythropoietin stimulates the production of erythrocytes in the bone marrow.
These erythrocytes leave the bone marrow and move into the blood stream.
Thrombocytopoiesis:
platelets originate by fragmentation at the ends of cytoplasmic processes extending from Megakaryocyte (a giant cell with irregularly lobulated polyploid nuclei) in bone marrow, each megakaryocyte can producea few thousand platelets.
Thrombopoietin stimulates
megakaryocytes and
platelet production.